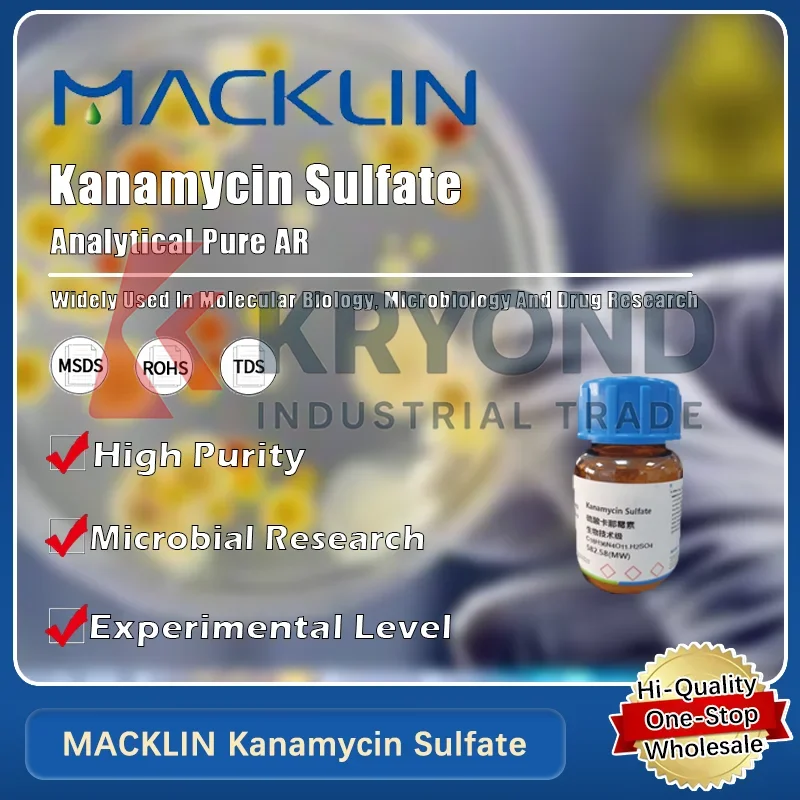
Биологический реагент MACKLIN Kanamycin Sulfate для микробиологических и фармацевтических исследований, оригинальный продукт

Multi-function Meat Grinder Manual Operation Meat/Vegetables Cutting Machine









sku: 32814776399
ACCORDING TO OUR RECORDS THIS PRODUCT IS NOT AVAILABLE NOW
$17.51
Shipping from: China
Technical Details
| Brand Name: | LAOWAI |
| Certification: | CB,CSA,CE |
| Housing Material: | PP |
| Model Number: | CJ-323 |
| Power W: | 0W |
| Use: | family |
Price history chart & currency exchange rate
Customers also viewed

$6.12
2Pcs Bread Rack Pan Nonstick Loaf Bakeware Tray French Bread Mold Baking Tool Perforated Design Safe Durability Gift
aliexpress.ru
$193.80
Печатающая головка для Canon IMAGE PROGRAF для Canon Pro 520 540S 540 560S 560 1000 2000 4000S 4000 PF 10 PF-10
aliexpress.ru
$2.12
1Pcs TC FKM Oil Seal Brown Fluorine Rubber Gasket Rings Cover Double Lip With Spring For Bearing ID*OD*THK 70/72/74/80/82/85MM
aliexpress.ru
$7.96
Black and White Wall Art Canvas Painting Indoor New Zealand Abstract Leaves Poster Decoration Pictures for Living Room Frameless
aliexpress.ru
$26.67
Винтажное платье для девочек, детские платья с бантом и пышными рукавами, платье для выступления на сцене, детская одежда для дня рождения
aliexpress.ru
$7.29
Новинка 2022, осенне-зимние женские зимние сапоги, женская обувь на платформе, теплые модные бархатные сапоги с круглым носком для женщин, жен...
aliexpress.ru
$2,356.47
ZONESUN Induction Sealer Aluminum Foil Pointed Tip Top Plastic Lid Bottle Twist Top Cap Sealing Machine Production ZS-FK6000
aliexpress.com
$31.39
Сумка-клатч из ротанга Женская водонепроницаемая, Пляжная плетеная Сумка-тоут для отдыха, 3 шт., на лето
aliexpress.ru
$9.16
M-2XL топ на бретелях и штаны, комплект из 2 предметов, Дамская пижама, пикантная одежда для сна с v-образным вырезом и открытой спиной, летняя Но...
aliexpress.ru
$3.54
Синяя портативная шлифовальная машинка для заточки бит с розовым корундовым шлифовальным кругом для спиральной дрели с прямым хвостовиком
aliexpress.ru
$2.68
Party Supplies Golden Stripe Plastic Disposable Drinking Straw Birthday Party Decorations Desechables Fiesta For Party 25pcs/Lot
aliexpress.com
$10.70
dog apparel winter clothes warm fleece pet coat jacket small hoodie for chihuahua sweatshirt puppy cat pullover clothing
dhgate.com
$63.28
Wizard School Hufflepuff Ravenclaw Slytherin Cosplay Costume Sweatshirts Uniform Embroidery Hoodie Thick Velvet Coat Sweater Y0913
dhgate.com
$8.92
Увеличительное стекло с светильник кой, 3,5x 25X увеличение светодиодный Ной подсветкой, ручное или подставное увеличительное стекло
aliexpress.ru
$10.99
Эспадрильи, мужская повседневная обувь, дышащие кроссовки, летняя классическая мужская обувь, лоферы для мужчин, дешево, размер 47
aliexpress.ru
$36.04
Крышка для зеркала заднего вида, 1 пара, левое и правое крыло автомобиля, декоративная крышка, подходит для Toyota Highlander 2008 2009 2010 2011 2012 2013
aliexpress.ru
$2.55
Гаечный ключ с двойной головкой и открытым концом, 6-25 мм, гаечный ключ для автомобиля, механический инструмент для ремонта велосипедов, гаеч...
aliexpress.ru
$89.43
desk & table clocks automatic flip clock mini scale retro stainless steel internal gear operated quartz home decor1
dhgate.com
$6.74
Cartoon tshirt Casual Women's T-shirt Ulzzang Harajuku T shirt 90s Girls Tshirt 2021 Summer Tshirt Lovely Hedgehog Tshirt
aliexpress.com
$12.65
1080P Новая мини-камера ночного видения X5 Портативная HD WIFI камера Спальня Офис Мобильный мониторинг Беспроводная камера мониторинга
aliexpress.ru
$255.15
234428 M SP BTW BM1 P5 прецизионный станок Подшипники Двусторонние подарки Контактные упорные шарикоподшипники Супер - точность
aliexpress.ru
$3.52
20 шт. оригинальный новый разъем 55932-0210 559320210 0559320210 2-контактный разъем, шаг 2,0 мм
aliexpress.ru
$17.80
400 Вт 220 В 110 В сценическая машина для запотевания дыма, нагреватель, запасная дезинфекция, распылитель, распылитель, распылитель, нагрев
aliexpress.ru
$35.58
Foamlina Вязаное платье с бретельками на бретельках в европейском стиле INS Pure Desire Hot Girl Design Sense с разрезом и завязкой на талии Платье макси
aliexpress.ru
$36.07
Калиброванный пружинный темпер для эспрессо с постоянной силой давления и волнообразным основанием, инструмент для приготовления кофе
aliexpress.ru
$21.50
Спортивный ремешок для Huawei Watch GT5 Pro 42 мм, силиконовый ремешок для умных часов Huawei Watch GT5 GT4, 41 мм, быстросъемный ремешок 18 мм
aliexpress.ru
$2,324.87
F185 Европейское украшение, шкаф для телевизора, ящики, коричневый шкаф для хранения, роскошный шкаф для телевизора, гостиная, скандинавская мебель для телевизора Szafka Pod
aliexpress.ru
$2,140.15
2279383 Насос GP-GEAR подходит для запасных частей оборудования Caterpillar 854G 854K D11N D11R D11T Гидравлический насос в сборе
aliexpress.ru
$41.97
Педаль эффектов для гитары AROMA ADT-3, дисторшн, высокая интенсивность усиления, true bypass, запчасти и аксессуары для электрогитары
aliexpress.ru
$59.86
2-конформерная походная плита, газовая портативная походная плита, походная плита с противнем для выпечки и портативным футляром
aliexpress.ru
$65.47
Элегантная юбка А-силуэта с кружевными вставками, женская, роскошная, с бриллиантовым декором, повседневная, с высокой талией, из полиэфирного волокна
aliexpress.ru
$33.72
Винтажная вязаная юбка с бахромой для женщин, в стиле Fair Isle, осенне-зимняя, с высокой талией, А-силуэт, повседневная одежда
aliexpress.ru
$28.04
Auto Shutdown Moisture Tester For Woodworking Construction Measurement Mode 831F
aliexpress.com
$11.52
Карабин для скалолазания 23KN, автоматические блокирующие крючки, прочные D-образные зажимы для карабина для такелажа, гамаки, веревки для домашних животных, тренировка спуска
aliexpress.ru
$20.79
Художественный набор для рисования лица, активируемая водой палитра красок для тела для косплея, фестиваля, Хэллоуина для детей и взрослых
aliexpress.ru